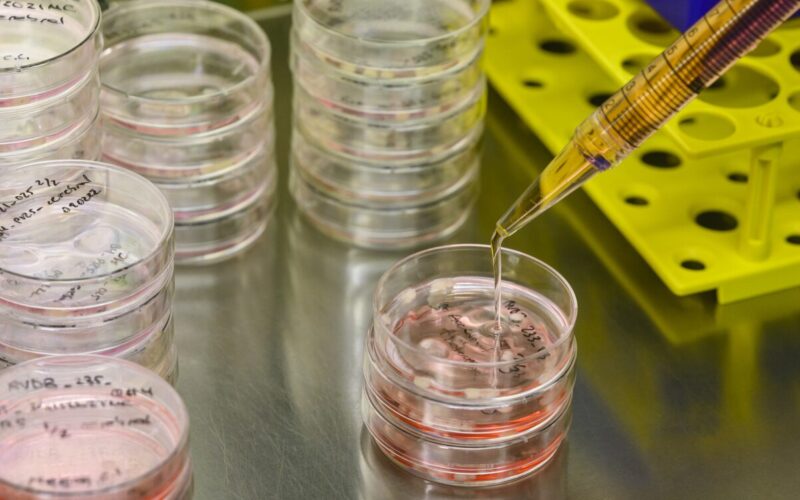
A pipet hovers over a petri dish

Research into brain diseases frequently concentrates on neurons, yet they might only reveal part of the story. Rather, the helper cells known as glia could hold the answers to the disrupted neuronal communication seen in numerous brain diseases. Specifically, an upregulated state of glia known as reactive gliosis is suspected to be a key pathological factor in disease onset and progression. Now, a new BRAINS grant will support a four-year study into the behavior of glial cells in various brain diseases such as dementia, MS, epilepsy and other neurological diseases.
The GLIODEM BRAINS project will see top Dutch glia biologists and neuroscientists partner with Swiss biotech company GliaPharm to deliver new insights. The project aims to uncover the consequences of reactive gliosis on neuronal functioning using human in vitro models. This collaborative effort combines academic expertise and industry innovation to advance our understanding of brain diseases, potentially paving the way for innovative treatments targeting glia.
Arthur Ermakov, Elly Hol, and Christiaan Huffels
Translational Neuroscience researchers Elly Hol, Jeroen Pasterkamp, Frank Meye, Christiaan Huffels, Elena Daoutsali, Laura Pieper and new PhD student Arthur Ermakov will collaborate with GliaPharm to measure changes in neuron-glia interaction in human iPSC and organoid models. They will develop new readouts and test novel pharmacological and genetic approaches to ameliorate reactive gliosis.
The models used in the project include both astrocytes and microglia, providing a clearer, more relevant picture of how cell types interact and cause network-wide effects in conditions of stress and toxicity.
“Previously, most brain research focused on neurons in brain disease, says Elly. “Fortunately, more and more attention is now being paid to the behavior of glial cells, which offers new opportunities for drug development. In our lab, a team is working on innovative techniques to better study gliosis. Together with GliaPharm, we will research new medicines that specifically target gliosis, with the aim of better treating people with brain diseases in the future. We are very pleased with the funding from BRAINS, which makes this collaboration possible.”
GliaPharm’s scientific founder Prof. Pierre Magistretti adds, “This international collaboration blends unique academic and industrial expertise. Together, we aim to develop innovative models that mimic the fundamental dysfunctions of glial cells in various neurological diseases. These models will be crucial for creating novel therapies that specifically target glial cells, opening new horizons in the treatment of these conditions”.
The BRAINS partnership is a joint grant opportunity in which the following health funds join forces: Alzheimer Nederland, Stichting MS Research, EpilepsieNL and Hersenstichting.
BRAINS originated from the Netherlands Brain Initiative (Nationaal Plan Hoofdzaken), a movement dedicated to creating solutions for individuals with brain and/or psychological disorders. The Netherlands Brain Initiative achieves this by fostering connections across various disciplines and collaborating with other organizations.
This collaborative BRAINS project has been co-financed with a PPS grant provided by Health~Holland, Top Sector Life Sciences & Health, to stimulate public-private partnerships.
For more information about Health~Holland and the Netherlands Brain Initiative, please visit www.health-holland.com and www.nationaalplanhoofdzaken.nl.
GliaPharm is a Swiss biotech company that develops innovative approaches to treat neurological and psychiatric disorders. GliaPharm was created in 2016 as a spinoff company from the laboratory of Prof. Pierre Magistretti at the Swiss federal institute of technology (EPFL, Switzerland), a leading research laboratory in the field of brain metabolism and glial cell biology. GliaPharm has established a pipeline of compounds through its in-house proprietary drug discovery platform focused on glial cell function. These compounds aim at promoting brain energy metabolism by specifically targeting glial cells.